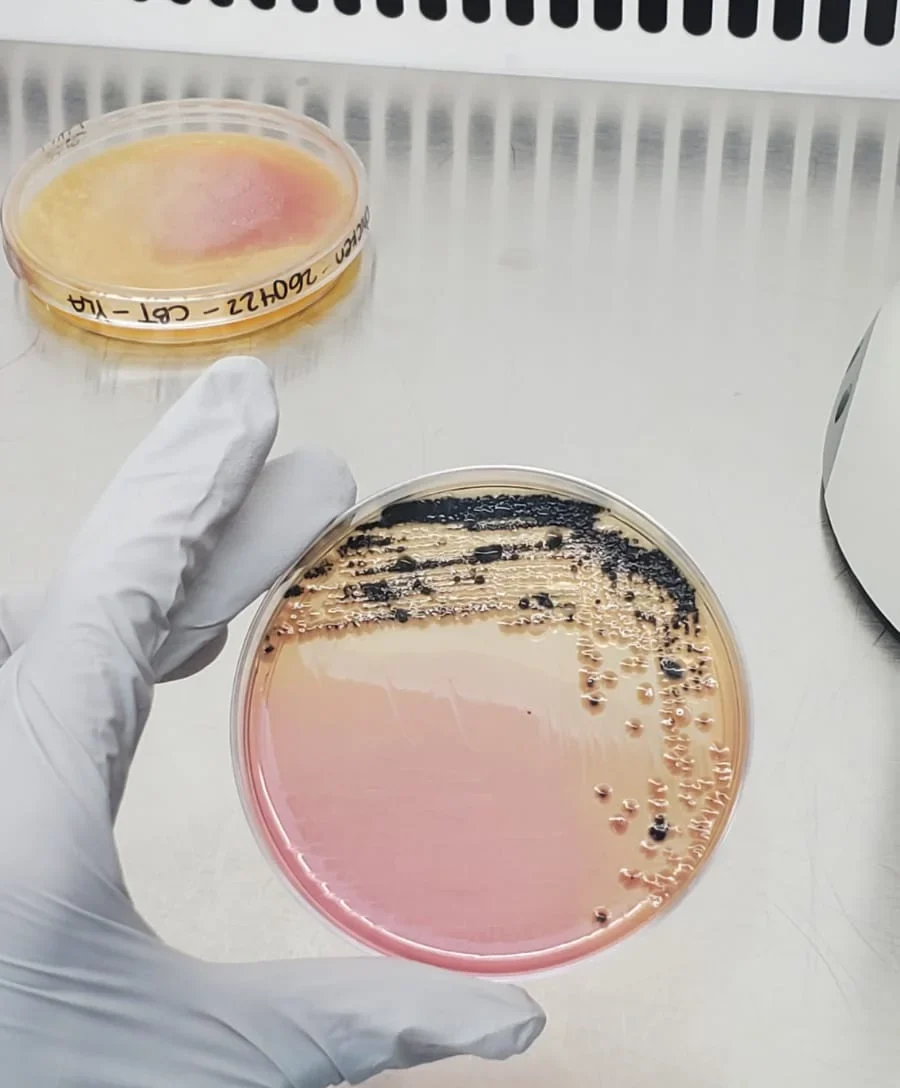
ANÁLISIS RÁPIDO DE SALMONELLA EN ALIMENTOS, MEDIANTE LA TÉCNICA ELFA

Descripción:
Se ofrece un servicio de análisis rápido de Salmonella en alimentos mediante técnicas inmunoenzimáticas. La detección de Salmonella, un agente común de intoxicaciones alimentarias se simplifica y acelera utilizando el ensayo VIDAS UP Salmonella, basado en la tecnología ELFA (Enzyme Linked Fluorescent Assay). Este método innovador utiliza proteínas recombinantes de fagos, permitiendo la detección de cepas móviles e inmóviles de Salmonella.
Nuestro Servicio:
El análisis inmunoenzimático se realiza después de una fase de enriquecimiento de 21 +/- 3 horas en «agua de peptona tamponada + suplemento Salmonella». La muestra se procesa en un cartucho con reactivos, se somete a termización y se analiza automáticamente en equipos VIDAS.
Este proceso incluye pipeteo con un cono recubierto de proteínas específicas para los receptores de Salmonella y la medición de fluorescencia a 450 nm mediante un sustrato fluorescente.
El instrumento analiza automáticamente los resultados, generando interpretaciones como positivo o negativo, con pruebas de confirmación adicionales en caso de resultado positivo.
Dirigido a empresas o centros de investigación que trabajan con harina integral, especialmente en el procesamiento de cereales y la producción de derivados como panes, galletas y bizcochos.
Nuestro Valor:
Este método ofrece tres ventajas clave: rapidez, sencillez y reducción de residuos.
Los resultados negativos se obtienen en solo 24 horas, en comparación con varios días requeridos por métodos normativos.
La simplicidad del proceso y la reducción de fases destacan la sencillez de esta técnica en comparación con la norma ISO.
Además, la minimización de residuos contribuye a prácticas más sostenibles en el análisis de Salmonella.
Este servicio está diseñado para empresas de alimentación humana que buscan eficiencia y confiabilidad en análisis rápidos de Salmonella.